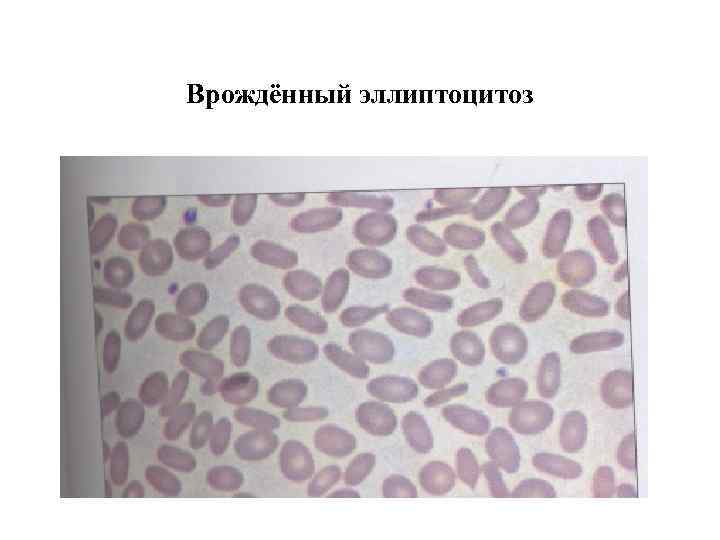
Врождённый эллиптоцитоз

Гемолитическая анемия проявляется характерной желтухой
Гемолитическая анемия проявляется характерной желтухой
 Вторичный гемохроматоз • Характерная пигментация кожи вледствие повышения уровня железа на фоне дилельно существующей хронической гемолитической анемии
Вторичный гемохроматоз • Характерная пигментация кожи вледствие повышения уровня железа на фоне дилельно существующей хронической гемолитической анемии
 Врождённый микросфероцитоз • Выраженная спленомегалия и умеренная гепатомегалия у девятилетнего мальчика
Врождённый микросфероцитоз • Выраженная спленомегалия и умеренная гепатомегалия у девятилетнего мальчика
 Врождённый микросфероцитоз. Картина периферичнской крови
Врождённый микросфероцитоз. Картина периферичнской крови
Врождённый эллиптоцитоз
Врождённый эллиптоцитоз
 Дефицит глюкозо 6 -фосфат дегидрогеназы – тельца Гейнца в эритроцитах
Дефицит глюкозо 6 -фосфат дегидрогеназы – тельца Гейнца в эритроцитах
 • Башенный череп у ребёнка с серповидноклеточно й анемией
• Башенный череп у ребёнка с серповидноклеточно й анемией
 Изменения костей черепа у больного с серповидноклеточной анемией
Изменения костей черепа у больного с серповидноклеточной анемией
 • Повышенная активность ростовых пластинок эпифиза у больного с талассемией
• Повышенная активность ростовых пластинок эпифиза у больного с талассемией
 Ретинопатия у больного с серповидноклеточной анемией • Окклюзия микрососудов сетчатки серповидноклеточны ми эритроцитами
Ретинопатия у больного с серповидноклеточной анемией • Окклюзия микрососудов сетчатки серповидноклеточны ми эритроцитами
 • Тяжёлый дактилит у ребёнка с серповидноклеточ ной анемией
• Тяжёлый дактилит у ребёнка с серповидноклеточ ной анемией
 Периферическая кровь при серповидноклеточной анемии.
Периферическая кровь при серповидноклеточной анемии.
 Периферическая кровь при малой талассемии. Эритроциты с гипохромией, мишеневидные эритрроциты, анизоцитоз и пойкилоцитоз
Периферическая кровь при малой талассемии. Эритроциты с гипохромией, мишеневидные эритрроциты, анизоцитоз и пойкилоцитоз
 Гемолиз с холодовыми агглютининами • Агглютинация при комнатной температуре (вверху) и отсутствие агглютинации в термостате при 370 С
Гемолиз с холодовыми агглютининами • Агглютинация при комнатной температуре (вверху) и отсутствие агглютинации в термостате при 370 С